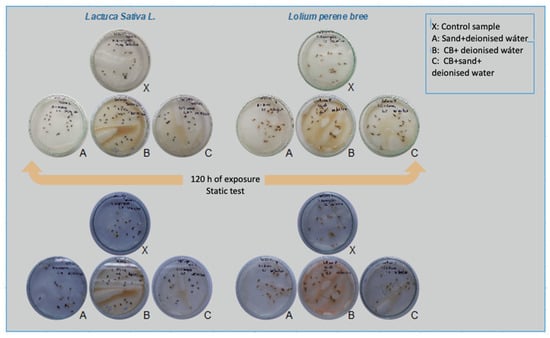

Abstract
Cigarette butts (CBs) are a major source of persistent pollution in coastal ecosystems, introducing harmful chemicals and microplastics into the environment. This study assesses the ecotoxicological impact of CB leachates on Marbella Beach, Chile, by analyzing the metal contamination and its phytotoxic effects on Lactuca sativa and Lolium perenne. Three scenarios were evaluated: CBs alone, CBs mixed with sand, and sand alone. Leachate analysis revealed significant concentrations of iron and zinc, with higher toxicity observed in scenarios involving CBs. Ecotoxicological assays demonstrated that cigarette butt leachates severely inhibited seed germination and plant growth, particularly in Lactuca sativa, which showed greater sensitivity compared to that of Lolium perenne. The results underscore the partial mitigating role of sand, although it was insufficient to prevent the toxic effects of CBs. The persistence of cellulose acetate in the environment and the continued release of hazardous chemicals highlight the ecological risks posed by cigarette butt pollution. These findings emphasize the need for improved waste management strategies and the development of biodegradable cigarette filters to reduce environmental contamination in coastal areas.
1. Introduction
The direct disposal of non-degradable waste into the environment is a major pollution problem worldwide. Throughout their existence, these wastes can damage nature in many ways. Among these, cigarette butts (CBs) are an important component of urban litter due to their large number and longevity. Approximately 15% of the world’s population smokes cigarettes. In addition, commercial cigarette sales total approximately USD 5.6 billion per year as of 2016 [1,2]. About 75% of smokers improperly dispose of their CBs, leading to widespread environmental contamination. CBs comprise the largest percentage of waste (approximately 19–38% of total waste by count) collected worldwide during coastal cleanups each year [3]. In Chile, data from the NGO Ocean Conservancy’s 2019 report indicated that 50.42% of the total waste collected during coastal cleanup campaigns consisted of CBs, highlighting the severity of this pollution in Chilean coastal areas (Figure 1) [4].

Figure 1.
Distribution of waste in Chilean coastal areas, according to Ocean Conservancy’s 2019 report [5].
Most CB filters are made of cellulose acetate, a non-biodegradable plastic derived from cellulose treated with acids and acetic anhydride, in the presence of catalysts. These filters, originally designed to retain tar and harmful products produced during tobacco combustion, contribute significantly to environmental pollution when discarded improperly [6]. Studies have demonstrated that the toxic substances leached from CBs—including nicotine, heavy metals (such as cadmium, lead, and arsenic), polycyclic aromatic hydrocarbons (PAHs), and various carcinogens—are highly detrimental to both terrestrial and aquatic organisms [4,7]. The environmental persistence of CBs can last between 7 to 25 years, with each CB capable of contaminating 8 to 10 L of salt water and up to 50 L of fresh water [4,8]. This prolonged persistence and high toxicity make CBs a significant environmental concern.
In addition to their contribution to heavy metal contamination, CBs are a source of persistent microplastics, further complicating their environmental impact. Cellulose acetate does not degrade easily under natural conditions but rather breaks down into smaller microplastic fragments which can infiltrate aquatic ecosystems and enter the food chain, exacerbating marine pollution. The toxic components of CB leachates have been detected in coastal waters, posing threats to marine life and potentially affecting higher trophic levels [9,10]. Furthermore, CB leachates have been shown to impair plant growth, with certain metals, such as cadmium and lead, accumulating in plant tissues and altering physiological processes [11]. Heavy metal uptake by plants can lead to stunted growth, reduced germination rates, and disruptions in nutrient cycling, impacting processes which are critical for ecosystem functioning [12].
These pollutants can cause acute toxicity in aquatic organisms; for example, Slaughter et al. [13] demonstrated that CB leachates could cause the death of 50% of exposed fish within 96 h and produce severe complications in aquatic invertebrates [13]. Additionally, the presence of nicotine and heavy metals in CB leachates poses a risk to marine biodiversity, as these substances can induce cellular stress, decalcification, and disrupted physiological processes in marine organisms such as foraminifera, leading to broader ecological disruptions [14].
CBs not only pose a threat to marine life but also present significant risks to plant species, which play critical roles in maintaining coastal ecosystem health. Leachates from CBs contain a complex mixture of toxic substances that can impair plant growth and development, underscoring the need for comprehensive assessments of their ecological impact [15]. For instance, heavy metals such as lead and cadmium, commonly found in CB leachates, can accumulate in plant tissues and disrupt physiological processes, potentially altering ecosystem functions [15]. Although extensive research has investigated the effects of CB leachates on aquatic organisms, limited studies have focused on their impact on plant species, which are essential for maintaining ecosystem health and stability.
Valparaíso, a region in central Chile, serves as a critical site for studying the impacts of CB pollution on coastal ecosystems. This area includes Marbella Beach and the Humedal y Estuario del Río Maipo Nature Sanctuary (Figure 2), which provide essential ecosystem services such as nutrient cycling, water purification, erosion control, and habitat for diverse flora and fauna [16]. Figure 2 illustrates the geographical location of Marbella Beach, highlighting its proximity to the Humedal y Estuario del Río Maipo Nature Sanctuary, a wetland of immense biological value due to its high biodiversity, particularly its large populations of marine and freshwater birds, 94% of which are endemic or native to Chile [16]. Soil biodiversity in Valparaíso plays a pivotal role in maintaining these functions, driving key processes like decomposition and nutrient cycling [17]. However, these vital ecosystems face increasing threats from pollution, including CB litter, which can degrade habitat quality and disrupt ecological balance. Addressing these threats is crucial, as the ecosystems of Valparaíso are vital for sustaining regional ecological integrity, particularly in the face of urbanization and land-use changes [17].

Figure 2.
Geographical location of Marbella Beach, Santo Domingo, Valparaiso Region, Chile.
This study aims to evaluate the environmental impact of CB leachates on coastal ecosystems by assessing their toxicity to selected plant species, specifically Lactuca sativa and Lolium perenne. These species, while not native to the Valparaíso Region, belong to the genus of monocotyledons and dicotyledons, respectively, a genus composed of more than 32 species, most of which are found in central Chile, from Coquimbo to the Bío-Bío Region [18]. These species were used as bioindicators due to their high sensitivity to pollutants and fast germination rates. Their established use in ecotoxicological studies provides reliable and reproducible data for assessing phytotoxicity, making them suitable for examining the environmental risks posed by CB contamination in the study area. By identifying the extent of phytotoxic effects, this research seeks to contribute to a broader understanding of the environmental risks associated with CB pollution and to inform policies and practices aimed at mitigating this pervasive form of litter.
2. Materials and Methods
2.1. Leachate Preparation for Toxicity Testing
The experiment was conducted in a controlled box (0.7 × 0.5 × 0.5 m), with black walls on all sides to minimize external light interference. The top of the box remained open to allow for the controlled entry of light, as shown in Figure 3. A full spectrum LED lamp (Progarden brand, model DIAMOND II 1000 W Double LED Chips, purchased through DEMASLED distributor with branch in Santiago de Chile) was suspended 0.5 m above the samples to provide consistent lighting. The lamp was connected to a timer, which was set for 10 h of light per day to mimic natural daylight cycles.

Figure 3.
Schematic of the experimental setup.
Three experimental scenarios were established: (A) control sample with sand only, (B) CBs only, and (C) a mixture of CBs and sand. Each scenario was tested in triplicate to ensure the reproducibility of the results.
2.1.1. Cigarette Butt Collection and Treatment
The CBs used in the study were collected from one of the most popular commercial cigarette brands in Chile [19,20]. Cigarettes were smoked voluntarily by a controlled group of students and faculty from the University of Santiago de Chile, and the butts (the CBs are 3 cm in length and 1 cm in diameter) were immediately sealed in individual airtight bags to prevent external contamination. The CBs were later cut into small pieces (approximately 1 cm) and ground to increase the surface area for leaching. Six grams of the ground material were added to 600 mL containers for scenarios B and C.
2.1.2. Sand Selection
In scenarios A and C, 200 g of beach sand was added to the containers. The sand used in this experiment was collected from a clean, uncontaminated beach in the Valparaíso Region; the sand was sieved to remove debris and washed with deionized water to ensure the removal of any impurities that could affect the results. The washed sand was oven-dried at 105 °C for 24 h before being used in the experiments.
2.1.3. Leachate Preparation
To prepare the leachates, 6 g of CB material was added to each container, as shown in Figure 3, along with 500 mL of ultrapure Milli-Q deionized water. Deionized water was specifically chosen to isolate the toxicological effects of CB leachates without additional environmental variables, such as salinity, that could influence metal leaching and toxicity. This approach allows for a focused assessment of the impact of CB components alone on the plant bioindicators.
The containers were gently agitated for 10 min to ensure full interaction between the water, CBs, and sand, simulating natural percolation conditions similar to those in a coastal environment after rainfall. The containers were left undisturbed for 24 h to allow sufficient leaching.
After the 24 h incubation period, the leachates were collected using sterile syringes designated for each container to prevent cross-contamination. The leachates were transferred into Eppendorf tubes and stored at 4 °C for preservation. After each leachate collection, the remaining water was returned to the containers for additional rounds of leaching, a process that was repeated three times to simulate ongoing environmental exposure.
2.2. Fourier Transform Infrared (FTIR) Spectroscopy Analysis
FTIR analysis was conducted to identify the functional groups present in the samples and to observe any modifications resulting from the CBs. The PerkinElmer Spectrum spectrometer, operating in the medium IR range (4500 cm−1 to 450 cm−1), was used. Samples from all scenarios (A: sand + DI water, B: CBs + DI water, and C: sand + CBs + DI water) were analyzed. After sample collection, they were sealed in Petri dishes and stored at 4 °C. Statistical analysis of the FTIR spectra was performed to assess any significant differences between scenarios.
2.3. Atomic Absorption Spectroscopy Analysis
Heavy metal concentrations in the leachates were determined using an atomic absorption spectrometer (Thermo Scientific, model ICE 3000 Series AA Spectrometer, available at the Faculty of Engineering of the University of Santiago de Chile), equipped with an air-acetylene flame. Previous studies have indicated that heavy metals exhibit varying leaching behaviors over time [21,22]. For instance, metals such as Ba, Fe, Mn, and Sr tend to show increasing concentrations in leachates over time, with Fe being particularly abundant. Conversely, metals like Ti, Pb, Zn, and Ni maintain low concentrations in the leachates, showing minimal change. In contrast, a decrease in concentration was observed for metals such as Cu, Al, Cr, and Cd, resulting in an almost negligible presence in the samples over time.
Based on these findings, we selected a representative metal from each of these behavior groups—Fe, Zn, and Cu—to verify these trends and assess their potential toxic effect on the study environment. To prevent capillary blockages, samples were filtered through 32 mm nylon syringe filters before analysis. Each sample was then acidified with 20 µL of ultrapure nitric acid (65%, Merck, Boston, MA, USA) to stabilize the metals for measurement. Standard metal concentrations were recorded using Thermo SOLAAR 11.10 software to ensure precise measurements.
2.4. Ecotoxicological Assay
To assess the phytotoxicity of the leachates derived from the different experimental scenarios, ecotoxicological assays were performed following standard methodologies widely used in environmental studies [23,24]. These assays focused on the inhibition of seed germination and the impairment of plant growth, which are reliable indicators of chemical toxicity in contaminated environments.
The species selected for the assay, Lactuca sativa and Lolium perenne, are commonly used bioindicator plants due to their sensitivity to pollutants. Lactuca sativa is photoblastic negative and requires darkness for germination, while Lolium perenne requires light for germination. Both species were used to assess the toxicity of the final leachates collected on day 37 of the experiment.
2.4.1. Experimental Procedure
Twenty seeds of each species (Lactuca sativa and Lolium perenne) were placed in sterile Petri dishes lined with filter paper. Each dish was saturated with 5 mL of the respective leachate from the different experimental scenarios. The dishes were sealed with parafilm to maintain moisture and prevent evaporation (Figure 4).
Figure 4.
Schematic of water toxicity test procedure using Lactuca sativa and Lolium perenne seed.
Given their photoblastic-negative nature, Lactuca sativa seeds were incubated in a germination chamber (RGX-250, Aolantec brand, from China) under constant darkness at 30 °C for five days. In contrast, Lolium perenne seeds were held under a 16/8 h light/dark photoperiod at 26 °C. This distinction ensured that each species was germinated under its optimal conditions to accurately assess the toxic effects of the leachates.
2.4.2. Parameters Measured
After a 120 h incubation period, the seed germination rates were recorded, and the radicle and shoot growth were measured. For Lactuca sativa, the radicle and hypocotyl lengths were measured, while for Lolium perenne, the radicle and coleoptile lengths were assessed. These measurements were used to calculate the following indicators:
- Relative Germination Percentage (RGP): A measure of the proportion of seeds germinated in the leachates compared to those germinated in deionized water (control).
- Germination Index (GI): Combines the germination rate with the radicle growth to assess the overall effect of the leachates on seedling development.
- Relative Radicle Growth (RRG): Compares the average radicle length of the seeds exposed to the leachates with that of seeds in the control.
- Hypocotyl/Coleoptile Growth (HG): Measures the growth inhibition of the hypocotyl (in Lactuca sativa) or coleoptile (in Lolium perenne) relative to that of the control.
The use of these standard phytotoxicity indicators allows for a robust evaluation of the toxic effects of CB leachates on seed germination and growth. The results were analyzed and compared to those for control samples to determine the extent of inhibition caused by the pollutants present in the CB leachates [23,24].
2.4.3. Statistical Analysis
The effects of leachate type on RGP, GI, RRG, and HG were analyzed by ANOVA. All data were analyzed using STATGRAPHICS 19.6.4 and a personal computer. A one-way ANOVA was performed to compare the mean results of the different scenarios. A within-class analysis of variance of the transformations was performed using Tukey’s test. When significant F values (0.05) were obtained, differences between individual means were tested using the least significant difference test.
3. Results and Discussion
3.1. Separation of Cigarette Butts
The residence time of CBs in each scenario extended beyond three days, allowing for the progressive release of chemical compounds into the surrounding medium. Previous studies have demonstrated that toxic substance, such as heavy metals and organic compounds, can leach into natural waters from CBs, which significantly affects the chemical profile of the leachate over time [25]. This differential release rate highlights the need for continued monitoring of leachate composition at multiple time points, as the concentration of hazardous components may increase or change depending on environmental conditions.
One notable difference among the scenarios was the color of the leachates. Sand-containing systems appeared to play a crucial role as a natural filtration medium, influencing the clarity and color of the leachates. Sand is frequently used as a filtration medium for water with low to medium pollutant loads, retaining particles as small as 20 microns. In this study, the sand effectively trapped various particulate and dissolved components from the CBs, reducing the visible contamination in the leachates. For example, in scenarios involving CBs, approximately 50% of a cigarette’s composition is comprised of tar and nicotine. These components are prone to transformation when exposed to water, leading to the formation of compounds like iron oxide, which likely contributed to the reddish-brown coloration observed in the leachates [10]. This filtration effect of the sand suggests that its natural ability to retain contaminants may reduce the visible impact of CBs, although further chemical analysis is necessary to confirm whether the sand has a buffering capacity for toxicity beyond mere filtration [26,27].
The leachate from scenario A (sand + deionized water) exhibited a distinct lead-gray color, attributed to the mineral composition of the sand. Microscopic analysis of sand from Marbella Beach, using a 64× zoom microscope, revealed a heterogeneous mixture of minerals, including quartz, epidote, zircon, garnet, limonite, biotite, and magnetite (Figure 5). Approximately 50% of these minerals are ferromagnesian, originating from volcanic processes, and contain iron and magnesium ions, which likely contribute to the dark color of the sand. The other 50% primarily consists of silicates like quartz, which appear more transparent under the microscope. This mineral diversity confirms the heterolithic nature of the sand, which has likely been formed from sediment transport originating from the Andes and the Chilean Coastal mountain ranges.

Figure 5.
Microscopic images of samples from the different scenarios analyzed: (A) cigarette butt, (B) sand, and (C) cigarette butt + sand.
In addition to color and mineral changes, daily pH measurements revealed a neutral to basic character across all scenarios (Figure 6). Initially, pH values were stable, but by day 20, the pH in the scenarios involving CBs (Scenarios B and C) began to rise sharply, reaching a maximum of 8.8 in Scenario C and 8.75 in Scenario B by the end of the 30-day period. This trend aligns with the release of nicotine and other alkaline compounds from the CBs, which are known to increase pH levels in aqueous environments. The control scenario (A), consisting only of sand and deionized water, maintained a relatively stable pH around 8.17, attributed to the carbonate content and other minerals leaching from the sand. These findings support the hypothesis that while sand can act as a filtration medium, it does not fully mitigate the release of alkaline substances from CBs, as indicated by the progressive rise in pH over time.

Figure 6.
pH analysis over time of the leachates in the different scenarios: CBs, CBs + sand, and sand alone. The results represent the mean of measurements performed in triplicate, with standard deviation values below 2%.
The leachate from scenario A (sand + deionized water) exhibited a pH of 8.17, likely due to the leaching of basic components from the sand, such as nutrients, salts, and elevated levels of phosphorus [28]. Additionally, carbonate ions present in the sand contributed to this pH increase [29]. In scenarios involving CBs, the pH levels were notably higher, reaching 8.8 in the combination of CBs and sand. This significant increase can be attributed to the alkaline properties of nicotine, a primary alkaloid in CBs, as well as other compounds present in the filter and tobacco remnants. Similarly, the pH in the scenario with only CBs reached 8.75, further supporting the association between nicotine and elevated pH levels in the leachates. The rise in pH from 8.17 to 8.8 represents a substantial shift towards alkaline conditions, which could have important implications for the surrounding environment, potentially altering soil chemistry, microbial activity, and nutrient availability in coastal ecosystems.
Throughout the experimental period, temperatures were consistently maintained between 20 °C and 24 °C, ensuring that pH variations were primarily influenced by the chemical interactions within the leachates rather than by external temperature fluctuations. This temperature stability supports the reliability of the pH data collected and ensures that observed pH differences are a result of the cigarette butt leachates and sand interactions rather than due to environmental factors.
3.2. FTIR Analysis
Figure 7 presents the FTIR spectra from triplicate analyses of the three scenarios: (A) sand + DI water, (B) CBs + DI water, and (C) CBs + sand + DI water. Additionally, the spectra of raw cellulose acetate are included for comparison. The spectra reveal several characteristic absorption bands that provide insights into the chemical composition of the samples and the stability of the cigarette butt components under different environmental conditions.

Figure 7.
FTIR spectra of samples from the scenarios compared with that of raw cellulose acetate [30].
In the O–H stretching region (3400–3200 cm−1), a broad, intense band is observed in all scenarios, although it is more pronounced in the CBs + DI water scenario (B) compared to the CBs + sand + DI water scenario (C) and the sand-only scenario (A). This O–H stretch, attributed to water molecules or hydroxyl groups, suggests that the CBs retain more moisture in the absence of sand. The lower intensity in scenario C is consistent with sand’s known filtration properties, which could reduce moisture retention.
Between 2850–2750 cm−1, weak bands corresponding to C–H stretching vibrations (associated with methyl groups) are visible across all scenarios, particularly in scenarios B and C. These C–H stretches likely arise from organic compounds such as the residual hydrocarbons in the CBs or from the cellulose acetate filter itself. The presence of these bands in the sand-containing scenario suggests that organic material from the CBs is still leaching into the environment, even in the presence of sand.
A distinct, sharp peak at 1750 cm−1 is visible in all scenarios involving CBs (B and C), as well as in the raw cellulose acetate spectrum. This peak corresponds to the C=O stretching vibration of the carbonyl group, typically associated with ester linkages in cellulose acetate [31]. In addition, in the case of the scenario containing CBs + sand, there is evidence of a peak in the 1700 cm−1, likely due to carboxyl groups, indicating the presence of acetic acid [32]. This finding suggests a degree of degradation of cellulose acetate, as the esterification of natural cellulose involves acetic acid [22]. The persistence of this peak across the scenarios indicates that the cellulose acetate filter remains chemically stable during the leaching process, and there is little evidence of degradation within the experimental timeframe.
In the fingerprint region, the band at 1375 cm−1 is attributed to the O(C=O)CH3 functional group, characteristic of acetates. This band is present in both scenarios involving CBs (B and C), as well as in the raw cellulose acetate spectrum, further indicating the stability of the acetate groups. Similarly, the band at 1240 cm−1, which represents C–O bond elongation, is consistent across the cigarette butt-containing samples and the raw cellulose acetate. These signals suggest that while the CBs leach some organic material, the primary chemical structure of the cellulose acetate filter remains intact.
The strong band observed at 1050 cm−1 in all scenarios reflects O–H bond elongation vibrations, commonly associated with hydroxyl groups from water or organic matter. Finally, the characteristic band at 615 cm−1 is present in both the cigarette butt-containing samples (B and C) and the raw cellulose acetate, confirming the presence of acetate groups in the leachates. This indicates that the acetate groups in the cigarette filters remain largely unaltered, even after exposure to sand and water.
Overall, the comparison with raw cellulose acetate and with the results of other studies [30,31,32,33] demonstrates that the primary functional groups—such as carbonyl (C=O), hydroxyl (O–H), and acetate (O(C=O)CH3)—remain chemically stable throughout the experimental period. This finding underscores the persistence of cigarette butt materials, particularly cellulose acetate, in natural environments. Despite environmental exposure, the functional groups show minimal modification, suggesting that CBs act as long-term pollutants, retaining their structure and potentially continuing to leach harmful substances into the environment over extended periods.
3.3. Chemical Content of Leachates
The chemical analysis of the leachates revealed notable differences in the concentrations of key metals, specifically iron (Fe) and zinc (Zn), across the three experimental scenarios (Figure 8). These variations can be attributed to the differing compositions of the CBs and the sand used in the experiments.

Figure 8.
Concentrations of iron (A) and zinc (B) in the leachates from the three analyzed scenarios.
3.3.1. Iron Concentrations
In the sand-only samples (Scenario A), the iron concentrations increased steadily over time, reaching a maximum of approximately 3 mg/L by week 5. This elevated iron content is attributed to the black sand used in the experiment, which is rich in iron-bearing minerals. The presence of iron in these samples reflects the leaching of iron from ferromagnesian minerals, which are common in volcanic sands like those found in the coastal regions of Chile.
In contrast, the iron concentrations in the cigarette butt-containing samples (Scenario B: CBs only and Scenario C: CBs + sand) were significantly lower. By week 5, the iron concentration in Scenario B reached only 0.59 mg/L, while in Scenario C, it was slightly higher at 0.89 mg/L. The lower iron concentrations in these scenarios can likely be attributed to the adsorption of iron onto the cigarette filter material, which may inhibit the complete leaching of iron from the sand. Previous studies have documented the tendency of cellulose acetate filters to adsorb metals, further supporting this observation [34]. The data suggest that the primary source of iron in the leachates is the sand component, and the CBs may act as sinks for some of the iron present in the system (Figure 8A).
3.3.2. Zinc Concentrations
The zinc concentrations were consistently low across all scenarios (Figure 9B). During the first week, the sand-only scenario (A) exhibited a zinc concentration of 0.162 mg/L, which was slightly higher than for the CBs-only scenario (0.150 mg/L) and the CBs + sand scenario (0.145 mg/L). However, after the first week, the zinc concentrations fluctuated and gradually decreased in all scenarios. By week 5, the zinc concentration in Scenario A had dropped to near-zero levels, while the cigarette butt-containing scenarios showed a slight increase in these levels.

Figure 9.
Relative germination percentage (RGP), germination index (GI), relative radicle growth (RRG), and relative hypocotyl growth (RHG) for the different scenarios. Statistical analyses were conducted using ANOVA and Tukey’s test (p < 0.05).
These low zinc concentrations may reflect the limitations of the analytical detection method used, as well as the possible interaction between zinc and other components in the leachates, such as organic matter from the CBs. The observed fluctuations may result from zinc’s tendency to form soluble complexes or precipitate under varying pH conditions, which could influence its availability in the leachates. Nevertheless, the overall zinc content remained low throughout the experimental period, suggesting limited zinc release from both the sand and CBs.
3.3.3. Copper Absence
No detectable copper (Cu) was found in any of the leachates, and therefore, no graphs were generated for this element. The absence of copper could be explained by its propensity to form insoluble compounds or complexes that may precipitate out or become filtered before analysis [35,36]. This highlights the importance of chemical interactions in the leachates, which can significantly affect the availability and detectability of certain metals. The lack of copper in the leachates aligns with the known behavior of copper in natural systems, where it readily forms complexes with organic and inorganic ligands, reducing its free concentration in solutions.
3.4. Ecotoxicological Assay Results
The ecotoxicological assay results demonstrate the significant impact of cigarette butt leachates on seed germination and early plant development. Figure 9 presents the relative germination percentage (RGP), germination index (GI), relative radicle growth (RRG), and relative hypocotyl growth (HG) for the three scenarios: sand (Scenario A), CBs + sand (Scenario C), and CBs only (Scenario B). The results highlight the role of sand in mitigating the toxic effects of CBs on plant growth, although CBs alone severely inhibited germination and growth.
3.4.1. Relative Germination Percentage (RGP)
The highest seed germination was observed in the sand leachate (Scenario A), with a mean RGP of 94.4%. This was followed by the CBs + sand leachate (Scenario C) at 50%, while the CBs-only leachate (Scenario B) had the lowest RGP at 5.55%. These results underscore the filtering role of sand, which helps reduce the toxicity of the cigarette butt leachates, likely by adsorbing or trapping harmful compounds. However, the significant reduction in germination in both scenarios involving CBs demonstrates the strong phytotoxic effects of the leachates.
3.4.2. Germination Index (GI)
The GI results further reflect the toxic impact of cigarette butt leachates on plant development. The sand leachate (Scenario A) had the highest GI at 30.93%, followed by the CBs + sand leachate (9.78%), while the CBs-only leachate had a drastically reduced GI of 0.13%. The near-zero GI in Scenario B indicates an almost complete inhibition of seedling development when exposed to cigarette butt leachates, even in the absence of additional soil media.
3.4.3. Relative Radicle Growth (RRG)
Radicle growth was also markedly affected by the cigarette butt leachates. In the sand-only scenario (A), RRG was recorded at 32.75%, while the CBs + sand scenario (C) exhibited a reduced RRG of 19.55%. The lowest RRG was observed in the CBs-only scenario (B) at 2.35%. The trend of reduced root growth with increasing exposure to cigarette butt leachates illustrates the severe toxicity of the leachates, which inhibits essential root elongation necessary for plant development.
3.4.4. Relative Hypocotyl Growth (HG)
In terms of HG, the sand-only scenario (A) resulted in a mean HG of 45.4%, while the CBs + sand scenario (C) showed a reduced HG of 31.07%. In stark contrast, the CBs-only scenario (B) completely inhibited hypocotyl growth, with an HG of 0%. This indicates that the leachates from CBs have a particularly strong inhibitory effect on hypocotyl elongation, which is critical for seedling emergence and survival.
3.4.5. Toxicity Assessment
Based on these results, the normalized residual germination percentage (RGP) and residual root elongation (RRE) indices were calculated using the methodology proposed by Bagur-González [37]. The RGP and RRE indices classify toxicity on a scale from −1 to >0, as follows: 0 to −0.25 (low toxicity), −0.25 to −0.5 (moderate toxicity), −0.5 to −0.75 (high toxicity), and values below −0.75 (extreme toxicity). Positive index values suggest radicle growth or hormesis. Table 1 summarizes the toxicity classification for the scenarios based on RGP and RRE for Lolium perenne.

Table 1.
Toxicity values with respect to RGP and RRE for Lolium perenne bree.
Further analysis of the Lolium perenne samples shows that the relationship between seed germination and radicle growth indicated moderate toxicity for the CBs-only leachate, demonstrating the significant impact of the leachate’s chemical composition on plant development. The sand + CBs scenario showed moderate toxicity based on RGP but exhibited better radicle growth than the control, indicating low toxicity overall. By contrast, the sand-only leachates exhibited minimal effects on germination and root elongation, classifying them as displaying low to moderate toxicity.
These findings align with studies conducted at Anglia Ruskin University (ARU, England) [38], which reported that CBs in soil reduced germination success and shoot length of clover (Trifolium repens) by 27% and 28%, respectively, and reduced root biomass by 57%. For Lolium perenne, germination success was reduced by 10% and shoot length by 13%. Notably, the ARU study also observed that unsmoked cigarette filters, composed of cellulose acetate—a bioplastic—fibers, had a similar negative effect on plant growth, suggesting that the filter material itself, even without the toxins from burned tobacco, is harmful to plants [39].
Considering the FTIR results from this study, which revealed the strong presence of cellulose acetate with minimal chemical variation over the analysis period, it is likely that the cigarette filter contributes significantly to the negative effects observed on plant growth. When comparing species sensitivity, Lactuca sativa showed higher sensitivity to the cigarette butt leachates compared to that of Lolium perenne, as evidenced by greater inhibition rates. This observation is consistent with the results of other studies, in which dicotyledonous plants like Lactuca sativa tend to be more sensitive to pollutants than are monocotyledonous species such as Lolium perenne. Consequently, it can be inferred that certain dicotyledonous plants, such as Docas, may be more adversely affected by cigarette butt leachates than are monocotyledonous plants like Totora. This study focused specifically on the impact generated by CBs in the proposed scenario; however, further studies will analyze whether the effect of water salinity has any additional consequences.
3.5. Environmental Applications and Ecological Implications
Our findings highlight the ecotoxicological risks posed by cigarette butt (CB) pollution in coastal ecosystems, particularly in plant bioindicators like Lactuca sativa and Lolium perenne. The persistence of cellulose acetate filters and the presence of harmful metals in CB leachates suggest that CB pollution can cause significant ecological disruptions, impairing plant growth and soil health over time. This emphasizes the importance of adopting multi-faceted strategies to mitigate CB pollution in coastal areas.
Efforts to address the environmental impact of CBs have primarily focused on cleanup initiatives, public awareness campaigns, and regulatory measures. However, these strategies often fall short due to the large volume of litter and persistent improper disposal by smokers [13]. Recent studies suggest that behavioral interventions, such as nudging strategies, can be effective in reducing CB littering. For example, Gay et al. [40] found that “social proof” and “dueling preferences” nudges in urban settings significantly reduced littering rates compared to traditional approaches [9]. Integrating behavioral science into environmental policy could strengthen CB mitigation efforts by introducing innovative solutions beyond conventional cleanup efforts.
Such behavioral interventions would complement our study’s findings, supporting an integrated approach that combines cleanup, policy, and behavioral strategies to more effectively reduce CB pollution in sensitive ecosystems. By merging public awareness with practical waste management solutions and behavioral insights, environmental policy could more comprehensively address both the source and the impacts of cigarette butt pollution in coastal ecosystems.
3.5.1. Long-Term Environmental Impact
CBs are among the most persistent forms of litter in natural environments, largely due to the slow degradation of their cellulose acetate filters. These filters act as reservoirs for pollutants such as nicotine and heavy metals, which are released into the surrounding environment over time. The severe inhibition of plant germination and root growth observed in this study indicates that cigarette butt pollution could have long-lasting effects on plant communities by preventing the regeneration of key species. Over time, this could lead to reduced biodiversity and impaired ecosystem functioning in affected areas [3,38,41,42,43].
3.5.2. Soil Health and Ecosystem Functionality
The presence of CBs in the environment may also impact soil health, which plays a critical role in supporting plant growth, nutrient cycling, and water filtration. Leachates from CBs have the potential to alter soil microbial communities, disrupt nutrient availability, and degrade overall soil quality. The results of this study, particularly the reduced radicle growth, suggest that cigarette butt leachates could limit plant root development, further affecting the ability of ecosystems to recover from disturbance. Healthy soils are essential for maintaining ecosystem resilience, and the introduction of pollutants like CBs could have cascading effects throughout the ecosystem [3,38,41,42,43].
3.5.3. Bioaccumulation and Food Chain Impacts
The stability of chemicals found in CBs, such as nicotine and heavy metals, raises concerns about their accumulation in plant tissues and potential bioaccumulation in higher trophic levels. This could pose risks not only to plant communities but also to herbivores and predators that rely on these plants as a food source. The long-term presence of these pollutants could lead to biomagnification, in which higher concentrations of toxins accumulate as they move up the food chain. This has profound implications for ecosystem health, particularly in biodiverse regions such as coastal areas where numerous species interact closely [3,38,41,42,43].
3.5.4. Relevance to Coastal Ecosystems in Chile
Chile’s coastal ecosystems, such as those in the Valparaíso Region, are particularly vulnerable to pollution from CBs due to the high density of urban and tourist activities in these areas. These ecosystems provide critical services, such as water purification, erosion control, and habitats for wildlife. The observed phytotoxicity of cigarette butt leachates to plant species like Lactuca sativa and Lolium perenne suggests that native plants, which are crucial for stabilizing coastal soils, may also be at risk. Disruption to these plant communities could lead to increased soil erosion and reduced habitat quality, further threatening biodiversity in these regions [44].
Given the significant environmental and ecological risks posed by cigarette butt pollution, it is crucial to implement waste management strategies that reduce cigarette litter. Public awareness campaigns, as well as the introduction of biodegradable filters, could mitigate the long-term impact of CBs on both soil health and plant communities.
4. Conclusions
This study provides critical evidence of the ecological risks associated with cigarette butt (CB) pollution, particularly within coastal ecosystems like Marbella Beach, Chile. The persistence of cellulose acetate, the primary component of cigarette filters, in all scenarios reinforces the understanding that CBs act as long-term environmental pollutants. This study found no significant degradation of cellulose acetate during the leaching process, highlighting its resilience and contribution to microplastic contamination in coastal areas. These findings align with those from previous research on the longevity of CBs in natural ecosystems, positioning them as a persistent form of pollution that continues to release toxic chemicals over time.
The chemical analysis of the leachates revealed the presence of harmful metals, notably iron (Fe) and zinc (Zn), with the highest concentrations observed in the sand-only scenario. However, the CBs acted as sinks for some metals, particularly in the CBs + sand scenario, showing lower metal leaching. While copper (Cu) was not detected, it is possible that the metal formed insoluble compounds, which either precipitated or were filtered out during the experimental setup. The accumulation of heavy metals from CBs highlights their potential to disrupt soil chemistry and alter nutrient availability in ecosystems.
Ecotoxicological assays conducted on Lactuca sativa and Lolium perenne demonstrated the severe phytotoxicity of cigarette butt leachates. Lactuca sativa was especially sensitive, showing drastically reduced germination and growth rates, while Lolium perenne exhibited moderate resilience but still faced significant growth inhibition. The sand, while acting as a partial filter, did not eliminate the harmful effects of CBs, indicating that even in mixed environmental conditions, CBs can have lasting detrimental effects on vegetation. The differential sensitivity between the two plant species suggests that local biodiversity could be compromised, particularly in regions where dicotyledonous plants play a crucial ecological role. The inhibition of root and shoot growth observed in this study further underscores the potential for cigarette butt leachates to impede plant regeneration, which could have cascading effects on ecosystem structure and function.
The findings emphasize the pressing need for effective waste management solutions, such as public awareness campaigns, biodegradable filter alternatives, and stricter regulations regarding cigarette littering, especially in environmentally sensitive areas like coastal ecosystems. Given the ubiquity of CBs as a pollutant and their documented impact on soil and plant health, future research should focus on the long-term ecological consequences of cigarette butt pollution, including its role in microplastic contamination, bioaccumulation in food chains, and the broader effects on biodiversity and ecosystem services.
Moreover, this study provides a foundation for policymakers and environmental organizations to advocate for enhanced waste management practices and the introduction of more sustainable tobacco product alternatives. Addressing cigarette butt pollution through integrated environmental strategies is crucial for mitigating its lasting impact on global ecosystems, especially as urbanization and tourism continue to increase pressures on coastal and marine environments. The long-term persistence and toxicity of CBs call for urgent action to safeguard the health and resilience of these critical ecosystems.
Author Contributions
Conceptualization, R.A.G.L.; methodology, R.A.G.L., J.P.K. and C.O.C.; software, R.A.G.L. and J.P.K.; validation, J.P.K., C.O.C., M.F.B.G., C.C.S.S. and R.M.S.; formal analysis, R.M.S.; investigation, M.F.B.G. and C.C.S.S.; resources, R.A.G.L.; data curation, M.F.B.G. and C.C.S.S.; writing—original draft preparation, R.M.S.; writing—review and editing, R.M.S.; visualization, R.A.G.L.; supervision, R.A.G.L.; project administration, R.A.G.L.; funding acquisition, R.A.G.L. All authors have read and agreed to the published version of the manuscript.
Funding
This research received no external funding, and the APC was funded by the Faculty of Engineering of Universidad de Santiago de Chile.
Institutional Review Board Statement
Not applicable.
Informed Consent Statement
Not applicable.
Data Availability Statement
The data presented in this study are available on request from the corresponding author.
Conflicts of Interest
The authors declare no conflicts of interest.
References
- Wipfli, H. The Tobacco Atlas, Fourth Edition. Am. J. Epidemiol. 2012, 176, 1193. [Google Scholar] [CrossRef]
- Dai, X.; Gakidou, E.; Lopez, A.D. Evolution of the global smoking epidemic over the past half century: Strengthening the evidence base for policy action. Tob. Control 2022, 31, 129–137. [Google Scholar] [CrossRef] [PubMed]
- Novotny, T.E.; Slaughter, E. Tobacco Product Waste: An Environmental Approach to Reduce Tobacco Consumption. Curr. Environ. Health Rep. 2014, 1, 208–216. [Google Scholar] [CrossRef] [PubMed]
- Araújo, M.C.B.; Costa, M.F. A critical review of the issue of cigarette butt pollution in coastal environments. Environ. Res. 2019, 172, 137–149. [Google Scholar] [CrossRef]
- Jones, J. The Beach and Beyond; Ocean Conservancy: Washington, DC, USA, 2019. [Google Scholar]
- Novotny, T.E.; Lum, K.; Smith, E.; Wang, V.; Barnes, R. Cigarettes Butts and the Case for an Environmental Policy on Hazardous Cigarette Waste. Int. J. Environ. Res. Public Health 2009, 6, 1691–1705. [Google Scholar] [CrossRef]
- Wright, S.L.; Rowe, D.; Reid, M.J.; Thomas, K.V.; Galloway, T.S. Bioaccumulation and biological effects of cigarette litter in marine worms. Sci. Rep. 2015, 5, 14119. [Google Scholar] [CrossRef]
- Kadir, A.A.; Sarani, N.A. Cigarette Butts Pollution and Environmental Impact—A Review. Appl. Mech. Mater. 2015, 773–774, 1106–1110. [Google Scholar] [CrossRef]
- Register, K. Cigarette butts as litter-toxic as well as ugly. Underw. Nat. 2000, 25, 23–29. [Google Scholar]
- Moerman, J.W.; Potts, G.E. Analysis of metals leached from smoked cigarette litter. Tob. Control 2011, 20 (Suppl. S1), i30–i35. [Google Scholar] [CrossRef]
- Beutel, M.W.; Harmon, T.C.; Novotny, T.E.; Mock, J.; Gilmore, M.E.; Hart, S.C.; Traina, S.; Duttagupta, S.; Brooks, A.; Jerde, C.L. A review of environmental pollution from the use and disposal of cigarettes and electronic cigarettes: Contaminants, sources, and impacts. Sustainability 2021, 13, 12994. [Google Scholar] [CrossRef]
- Rashid, A.; Schutte, B.J.; Ulery, A.; Deyholos, M.K.; Sanogo, S.; Lehnhoff, E.A.; Beck, L. Heavy metal contamination in agricultural soil: Environmental pollutants affecting crop health. Agronomy 2023, 13, 1521. [Google Scholar] [CrossRef]
- Slaughter, E.; Gersberg, R.M.; Watanabe, K.; Rudolph, J.; Stransky, C.; Novotny, T.E. Toxicity of cigarette butts, and their chemical components, to marine and freshwater fish. Tob. Control 2011, 20 (Suppl. S1), i25. [Google Scholar] [CrossRef] [PubMed]
- Sabbatini, A.; Caridi, F.; Birarda, G.; Costanzi, E.; Amici, A.; Mobbili, G.; Buosi, C.; De Giudici, G.; Medas, D.; Negri, A. Response of Foraminifera to Anthropogenic Nicotine Pollution of Cigarette Butts: An Experimental Approach. J. Mar. Sci. Eng. 2023, 11, 1951. [Google Scholar] [CrossRef]
- Dobaradaran, S.; Soleimani, F.; Akhbarizadeh, R.; Schmidt, T.C.; Marzban, M.; BasirianJahromi, R. Environmental fate of cigarette butts and their toxicity in aquatic organisms: A comprehensive systematic review. Environ. Res. 2021, 195, 110881. [Google Scholar] [CrossRef] [PubMed]
- Parra, B.G.; Osorio, Q.P.; González, C.D. Donde se Junta el río y la Memoria: Reflexiones en Torno al Humedal río Maipo y el ex Centro de Detención “Cabañas de Santo Domingo”. Ph.D. Dissertation, Pontificia Universidad Católica de Valparaíso, Valparaíso, Chile, 2022. [Google Scholar]
- Marín, C.; Rubio, J.; Godoy, R. Chilean blind spots in soil biodiversity and ecosystem function research. Austral Ecol. 2022, 47, 1372–1381. [Google Scholar] [CrossRef]
- Fariña, J.M.; Bertness, M.D.; Silliman, B.; Aragoneses, N.; Gayo, E. Natural History and Environmental Patterns in the El Yali Coastal Wetland, Central Chile. In The Ecology and Natural History of Chilean Saltmarshes; Springer: Cham, Switzerland, 2017; pp. 169–193. [Google Scholar]
- Thrasher, J.F.; Islam, F.; Barnoya, J.; Mejia, R.; Valenzuela, M.T.; Chaloupka, F.J. Market share for flavour capsule cigarettes is quickly growing, especially in Latin America. Tob. Control 2017, 26, 468–470. [Google Scholar] [CrossRef]
- Paraje, G.; Araya, D.; Drope, J. The association between flavor capsule cigarette use and sociodemographic variables: Evidence from Chile. PLoS ONE 2019, 14, e0224217. [Google Scholar] [CrossRef]
- Soleimani, F.; Dobaradaran, S.; Vazirizadeh, A.; Mohebbi, G.; Ramavandi, B.; De-la-Torre, G.E.; Nabipour, I.; Schmidt, T.C.; Novotny, T.E.; Maryamabadi, A. Chemical contents and toxicity of cigarette butts leachates in aquatic environment: A case study from the Persian Gulf region. Chemosphere 2023, 311, 137049. [Google Scholar] [CrossRef]
- Kurmus, H.; Mohajerani, A. The toxicity and valorization options of cigarette butts. Waste Manag. 2020, 104, 104–118. [Google Scholar] [CrossRef]
- Parada, R.; Barros, D.; Cotoras, M.; Ortiz, C. Colonización de Lolium perenne y Polypogon australis por hondos endófitos obtenidos de Poáceas provenientes de un relave minero de Puerto Cristal, Chile. In Proceedings of the Jornadas de Jóvenes Investigadores AUGM, Mendoza, Argentina, 17–19 October 2018. [Google Scholar]
- Ortiz, C.; Palma, J.; Valenzuela, P. Rehabilitation and Landscape Integration of a Tailings Deposit in Atacama, Chile. In Proceedings of the 9th World Congress on New Technologies, NewTech 2023, London, UK, 9–11 August 2023; Avestia Publishing: Orléans, ON, Canada, 2023. [Google Scholar]
- Dobaradaran, S.; Schmidt, T.C.; Kaziur-Cegla, W.; Jochmann, M.A. BTEX compounds leachates from cigarette butts into water environment: A primary study. Environ. Pollut. 2021, 269, 116185. [Google Scholar] [CrossRef]
- Abdiyev, K.; Azat, S.; Kuldeyev, E.; Ybyraiymkul, D.; Kabdrakhmanova, S.; Berndtsson, R.; Khalkhabai, B.; Kabdrakhmanova, A.; Sultakhan, S. Review of slow sand filtration for raw water treatment with potential application in less-developed countries. Water 2023, 15, 2007. [Google Scholar] [CrossRef]
- Liu, L.; Fu, Y.; Wei, Q.; Liu, Q.; Wu, L.; Wu, J.; Huo, W. Applying Bio-Slow Sand Filtration for Water Treatment. Pol. J. Environ. Stud. 2019, 28, 2243–2251. [Google Scholar] [CrossRef] [PubMed]
- Zeb, J.; Wasim, M.; Shah, S.A.; Khanam, S.; Tahir, H.; Qadri, M. Characterization of sand samples from Karachi beaches using gamma spectrometry and Xrd. Radiat. Prot. Dosim. 2020, 189, 234–241. [Google Scholar] [CrossRef] [PubMed]
- Erisoz Kasap, O.; Linton, Y.-M.; Karakus, M.; Ozbel, Y.; Alten, B. Revision of the species composition and distribution of Turkish sand flies using DNA barcodes. Parasites Vectors 2019, 12, 410. [Google Scholar] [CrossRef]
- Rhein, F.; Sehn, T.; Meier, M.A. Degree of Substitution of Cellulose Acetate and Other Esters: Raw ATR-FTIR Spectra and DS Data Obtained from IR Integration, 1H NMR and 31P NMR; IOC: Vigo, Spain, 2024. [Google Scholar]
- Blatchford, M.A.; Raveendran, P.; Wallen, S.L. Spectroscopic Studies of Model Carbonyl Compounds in CO2: Evidence for Cooperative C−H···O Interactions. J. Phys. Chem. A 2003, 107, 10311–10323. [Google Scholar] [CrossRef]
- Battisti, R.; Hafemann, E.; Claumann, C.A.; Machado, R.A.F.; Marangoni, C. Synthesis and characterization of cellulose acetate from royal palm tree agroindustrial waste. Polym. Eng. Sci. 2019, 59, 891–898. [Google Scholar] [CrossRef]
- Yousef, S.; Eimontas, J.; Striūgas, N.; Praspaliauskas, M.; Abdelnaby, M.A. Pyrolysis kinetic behaviour, TG-FTIR, and GC/MS analysis of cigarette butts and their components. Biomass Convers. Biorefin. 2024, 14, 6903–6923. [Google Scholar] [CrossRef]
- Batley, G.E.; Campbell, P.G. Metal contaminants of emerging concern in aquatic systems. Environ. Chem. 2022, 19, 23–40. [Google Scholar] [CrossRef]
- Pan, H.; Zhao, X.; Zhou, X.; Yan, H.; Han, X.; Wu, M.; Chen, F. Research progress on the role of biofilm in heavy metals adsorption-desorption characteristics of microplastics: A review. Environ. Pollut. 2023, 336, 122448. [Google Scholar] [CrossRef]
- Filipović, L.; Defterdarović, J.; Chen, R.; Krevh, V.; Gerke, H.H.; Baumgartl, T.; Kovač, Z.; Ondrašek, G.; Ružičić, S.; He, H. Leached copper correlation with dissolved organic carbon in sloped vineyard soil. Water 2023, 15, 800. [Google Scholar] [CrossRef]
- Bagur-González, M.G.; Estepa-Molina, C.; Martín-Peinado, F.; Morales-Ruano, S. Toxicity assessment using Lactuca sativa L. bioassay of the metal (loid) s As, Cu, Mn, Pb and Zn in soluble-in-water saturated soil extracts from an abandoned mining site. J. Soils Sediments 2011, 11, 281–289. [Google Scholar] [CrossRef]
- Green, D.S.; Boots, B.; Carvalho, J.D.S.; Starkey, T. Cigarette butts have adverse effects on initial growth of perennial ryegrass (gramineae: Lolium perenne L.) and white clover (leguminosae: Trifolium repens L.). Ecotoxicol. Environ. Saf. 2019, 182, 109418. [Google Scholar] [CrossRef] [PubMed]
- Molukutla, A. Role of Cigarette Butt in poor plant growth and nitrate levels. J. Stud. Res. 2023, 12, 1–10. [Google Scholar] [CrossRef]
- Gay, A.; Pascual, A.; Salanova, T.; Felonneau, M.L. What about using nudges to reduce cigarette butts pollution? J. Hum. Behav. Soc. Environ. 2023, 34, 528–535. [Google Scholar] [CrossRef]
- da Silva, N.F.; de Araújo, M.C.B.; Silva-Cavalcanti, J.S. Cigarette butts in the environment: A growing global threat? Environ. Rev. 2023, 31, 229–242. [Google Scholar] [CrossRef]
- Vanapalli, K.R.; Sharma, H.B.; Anand, S.; Ranjan, V.P.; Singh, H.; Dubey, B.K.; Mohanty, B. Cigarettes butt littering: The story of the world’s most littered item from the perspective of pollution, remedial actions, and policy measures. J. Hazard. Mater. 2023, 453, 131387. [Google Scholar] [CrossRef]
- Schultz, P.W.; Mertens, S.N. If you want to change behaviour, start with the environment. In Handbook on Pro-Environmental Behaviour Change; Edward Elgar Publishing: Cheltenham, UK, 2023; pp. 372–386. [Google Scholar]
- De Veer, D.; Baeza-Álvarez, J.; Bolaños, S.; Araya, S.C.; Darquea, J.J.; Poblete, M.A.D.; Domínguez, G.; Holtmann-Ahumada, G.; Honorato-Zimmer, D.; Gaibor, N. Citizen scientists study beach litter along 12,000 km of the East Pacific coast: A baseline for the International Plastic Treaty. Mar. Pollut. Bull. 2023, 196, 115481. [Google Scholar] [CrossRef]
Disclaimer/Publisher’s Note: The statements, opinions and data contained in all publications are solely those of the individual author(s) and contributor(s) and not of MDPI and/or the editor(s). MDPI and/or the editor(s) disclaim responsibility for any injury to people or property resulting from any ideas, methods, instructions or products referred to in the content. |
© 2024 by the authors. Licensee MDPI, Basel, Switzerland. This article is an open access article distributed under the terms and conditions of the Creative Commons Attribution (CC BY) license (https://creativecommons.org/licenses/by/4.0/).